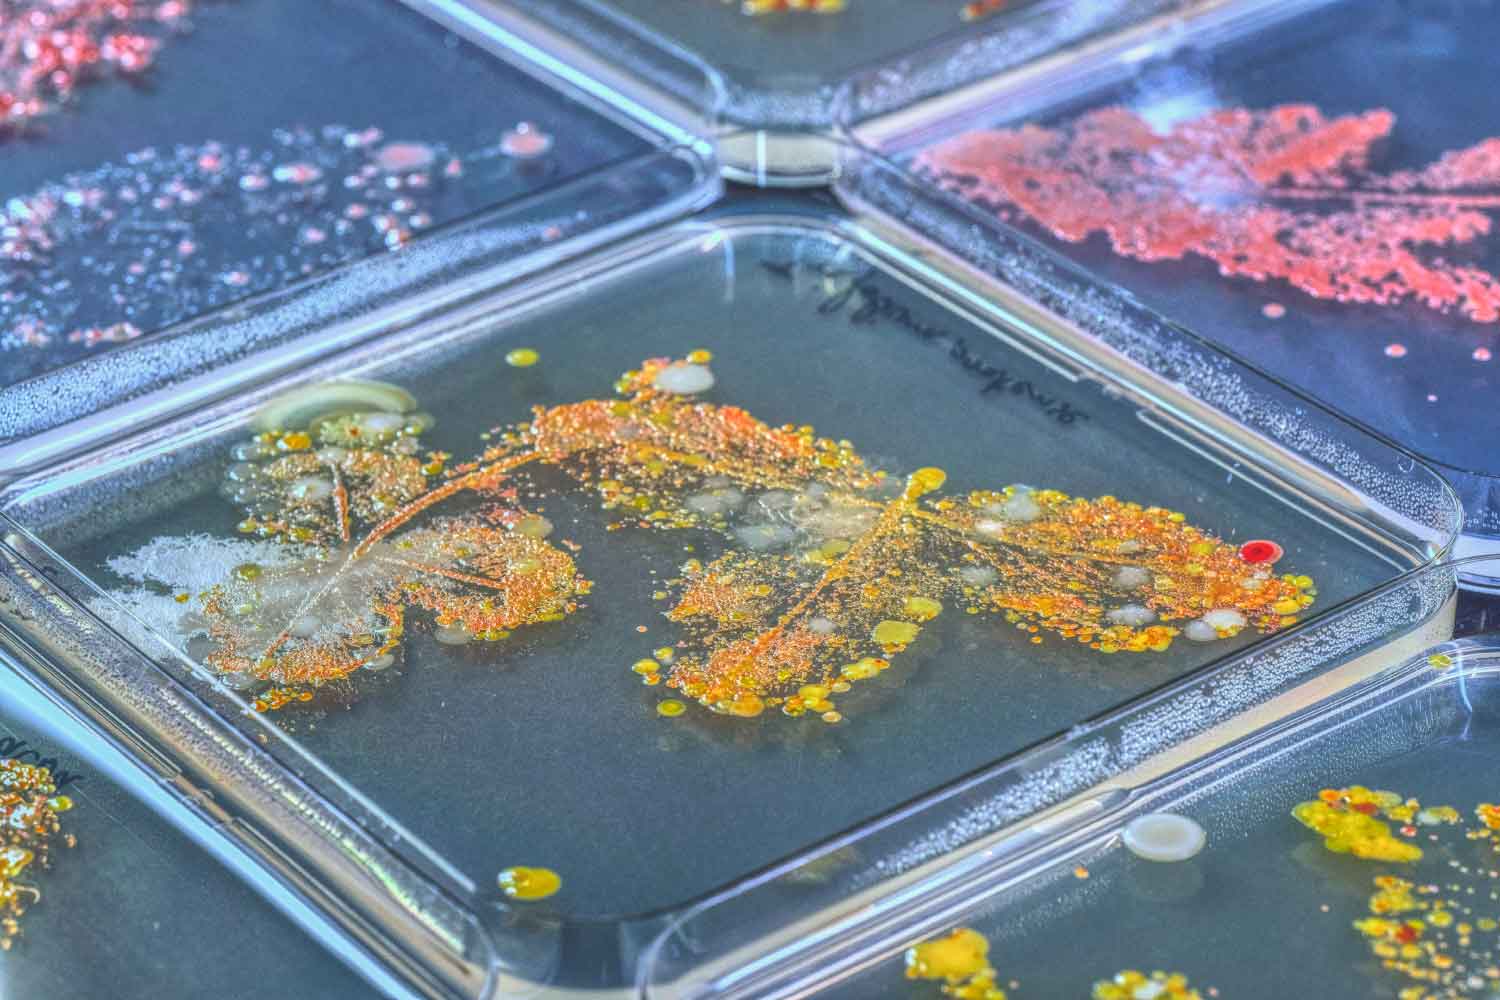
never-alone

Promega Art Contest for Creative Scientists
“The most beautiful thing we can experience is the mysterious. It is the source of all true art and science.”
Albert Einstein
It looks like you are having trouble logging in, please try our dedicated login page.
Thank you for verifying your email address.
There was an issue verifying your email address. Please try again or contact Customer Service.
Promega Art Contest for Creative Scientists
“The most beautiful thing we can experience is the mysterious. It is the source of all true art and science.”
Albert Einstein
The collection of 13 artworks selected by the Jury of Dr. Martin Oeggerli, Figure 1.A., and Dr. Joanna Stevenson.
This image shows bacteria growing from the imprint of various leaves on R2A agar plates, with a clover leaf prominently in the center. It reveals the hidden diversity and beauty of the microbiome living on plant surfaces, often overlooked. Contrasting with the smooth, perfect agar and the crisp edges of the plates, the growing colonies create a striking and vibrant explosion of colors. Originally created for a science outreach project, this image reminds us not to lose sight of the beauty of the whole, especially when we focus closely on individual parts. Every biological surface is colonized by microscopic life—no living thing is ever truly alone.
This confocal microscopy image captures a microscopic battle between antibiotic-resistant and -susceptible strains of Chlamydia suis, a zoonotic bacterium found in pigs. Transformed with fluorescent markers, the resistant strains appear as pink “fireworks”, the susceptible ones in green. Blue marks the nuclei and red delineates the cell membrane. Beyond its visual impact, the artwork reflects the urgency of antimicrobial resistance research and the hidden complexity of bacterial evolution—reminding us that even at the cellular level, resistance leaves a trace.


In clinical studies, every measurement matters. Sample volumes are limited, and results can guide treatment or shape the outcome of a PhD. This artwork overlays single measurements of cortisol and prednisolone metabolites, commonly termed stress hormones, quantified in human plasma using UHPLC-MS/MS. Each colorful chromatographic peak stands for more than data: it reflects trust in a carefully developed method and in an instrument affectionately called “Honey.” Behind the bright colors lie years of work, precision, and the potential to make a real difference.
A meteorite, bound in magnetized wooden rings and coated with ultra-black acrylic paint, forms the heart of this stunning gyroscopic sculpture. The piece highlights the Widmanstätten pattern—nickel-iron crystals that take millions of years to grow in the vacuum of space. To achieve the gyroscopic motion, non-magnetic ceramic bearings and carbon rods were used to avoid interference with the magnetic field. Though tricky to assemble, the result offers a playful, unpredictable spin, sometimes holding steady, sometimes jumping unexpectedly, echoing the tension between symmetry and chaos in space and physics.


This artwork explores how bacteria compete, cooperate, and coexist during host infection. Captured in the transparent zebrafish larva model, the digitally processed widefield microscopy image reveals the interplay between two fluorescently labelled bacterial strains, weaving a narrative that bridges traditional wet lab methods with advanced computational imaging. Beyond the science, it serves as a metaphor for the convergence of disciplines, innovation, and collaboration in scientific discovery. Highlighting the duality of a system that thrives on collaboration but can also be limited by its own inherently competitive nature, this piece invites reflection on the dynamics and careful balance between cooperation and competition in both microbial and human interactions.
Merging advanced light microscopy techniques and digital painting, this artwork celebrates the inherent beauty of nature and science. It depicts a pine hawk-moth's wing visualized on a light-sheet microscope after optical clearing, pigmentation removal, and sectioning, followed by digital coloring to reveal the intricate and complex patterns making up the moth wing's structure. Combining the artist's passions and role in both science and art, it serves as a reminder to appreciate the "little" things – those that might be invisible at a glance, but that reveal their intrinsic aesthetic beauty and complexity if one takes a closer look – like the elegant structural patterns of a moth’s wing.




Sometimes, all it takes to witness the beauty of life is to look beyond what’s in focus. This bright field microscopy image shows snail embryos, quietly growing beside the zebrafish embryos that scientists care for, experiment on, and use for imaging. The snails, unnoticed and uncelebrated, keep the aquarium clean, mere byproducts of zebrafish care. Out of focus, yet undeniably charming, intriguing, and precious. These tiny life forms offer a gentle reminder, that sometimes, the most intriguing things are simply waiting to be seen. Through microscopy, the artist found not just a technique, but a new way of noticing.


This collage translates functional magnetic resonance imaging (fMRI) scans into visual art, reflecting the brain’s structural and functional complexity. Based on a self-conducted brain scan during a linguistic task, the artwork explores hemispheric activation in Broca’s area, a region typically associated with speech, revealing bilateral activation of the brain. The collage technique, consisting of the assembly of multiple visual elements to create a unified composition, strikingly mirrors the brain’s integration of diverse neural networks to produce complex cognitive and linguistic functions. In this piece, scientific interpretation and artistic composition merge, reinforcing the idea that neurological activity can be both structurally intricate and aesthetically compelling.



Head of Marketing at Promega Switzerland, Knitwear designer and multi-crafter

Swiss photographer specializing in scientific microscopy and fine art

The Promega AG Art Contest for Creative Scientists (the “Art Contest”) is open to scientists who are at least 18 years old and are affiliated to a life science-related institution in Switzerland. The Art Contest is limited to one entry per person that has not been previously submitted to an Art Contest held by Promega or have received a prize in an art competition organized by any other entity. All Art Contest submissions must be submitted in a digital format using the online entry form. The submissions consist of the artwork and the descriptive document about the artwork and the techniques used.
As an eligible scientist, you must complete the entry form on this website and upload a digital image of your Art Contest submission prior to February 19, 2023, 11:59 pm Zurich time (the “Deadline”). The digital images can be submitted in PNG or TIFF format with a maximum size of 10MB with the highest resolution possible (not up-RESed). Digital touch-ups are permitted. Should your artwork be selected to be part of the collection (see below) you might be requested to deliver the image in highest resolution and image size possible. Art works created in collaboration between scientists and artists (or other professions) can be submitted, however only the scientist will be assigned as the author of the artwork. The contributors to the artwork should be mentioned in the artwork description. Only the first digital image submitted by the scientist by the Deadline with a completed entry form will be entered into the Art Contest (“Art Submission”). No Art Submissions will be accepted after the Deadline or in a wrong format. You must provide a valid email address affiliated to your institution as part of your entry form.
Please consider that your organization’s internal policy may not allow you to receive prizes or may require your employer’s permission before you submit an entry into the contest. You are solely responsible for compliance with your employer’s policies.
Employees of Promega AG and their immediate family members (spouses, parents, children, siblings and their respective spouses, regardless of where they live) are not eligible to enter the Art Contests.
All Art Submissions will be reviewed by a panel of judges presented on the current contest landing page, and a collection (“Art Collection”) will be created out of selected Art Submissions (that become “Art Images”). A grand prize winner and two runners-up will be selected within the Art Collection. The grand prize winner will receive a special recognition trophy designed by Martin Oeggerli and have their work displayed in an Art Exhibition (should an exhibition be organized). The grand prize winner and the two runners-up will receive winners’ certificates and dedicated copies of the album “Micronavigating Between Art and Science” by Martin Oeggerli. The Art Collection will be presented in a virtual exhibition on Promega.com. Please note that we will not link the entries in the virtual exhibition to any external sources/landing pages. We can, however, refer to the source in the text describing the artwork.
By participating, you warrant that all information provided is accurate, that you are the lawful owner of all intellectual property associated with your Art Submission, and that your participation in the Art Contest does not violate any applicable laws or regulations. Promega AG reserves the right to request proof that your Art Image is your original artwork created solely by you. Non-compliance with this rule may disqualify you from the Art Contest.
By participating, all entry information submitted by you as part of the Art Submission becomes property of Promega AG. You retain title and ownership of the Art Image but hereby grant Promega AG a non-exclusive license, irrevocable, royalty-free license to use the Art Image as described herein and to reproduce images of the Art Image in association with display, advertising, promotions, and/or marketing of the Promega AG Art Exhibition, at Promega’s discretion.
No prize transfer or cash redemption is permitted. No prize substitution is permitted, except by the sole discretion of Promega AG, in which case a prize of comparable or greater value will be awarded. You are solely responsible for paying all federal, cantonal, and local taxes on any prizes.
By participating, you agree to abide by and be bound by the rules and decisions of Promega AG which shall be final in all respects relating to this Art Contest, including without limitation to the interpretation of these rules. You agree to release, discharge and hold harmless Promega AG, affili¬ates, and their officers, directors, agents and representatives and their respective employees from any and all claims, charges, injuries, liability, losses and/or damages of any kind resulting from or arising out of your participation in the Art Contest, your violation of any third-party rights, and/or your acceptance, use, misuse or possession of any prize received through the Art Contest. Promega AG affili¬ates, and their officers, directors, agents and representatives and their respective employees are not responsible and shall not be liable for: (a) late entries for any reason; (b) any disruption, delay, modification, or discontinuance of the Art Contest and/or your Art Submission; or (c) your participation in the Art Contest. Promega makes no warranties of any kind in association with the Art Contest.
If, for any reason, the Art Contest is not capable of running as planned, because of causes beyond the control of Promega AG, Promega AG reserves the right, in its sole discretion, to cancel, terminate, modify, or suspend the contest.